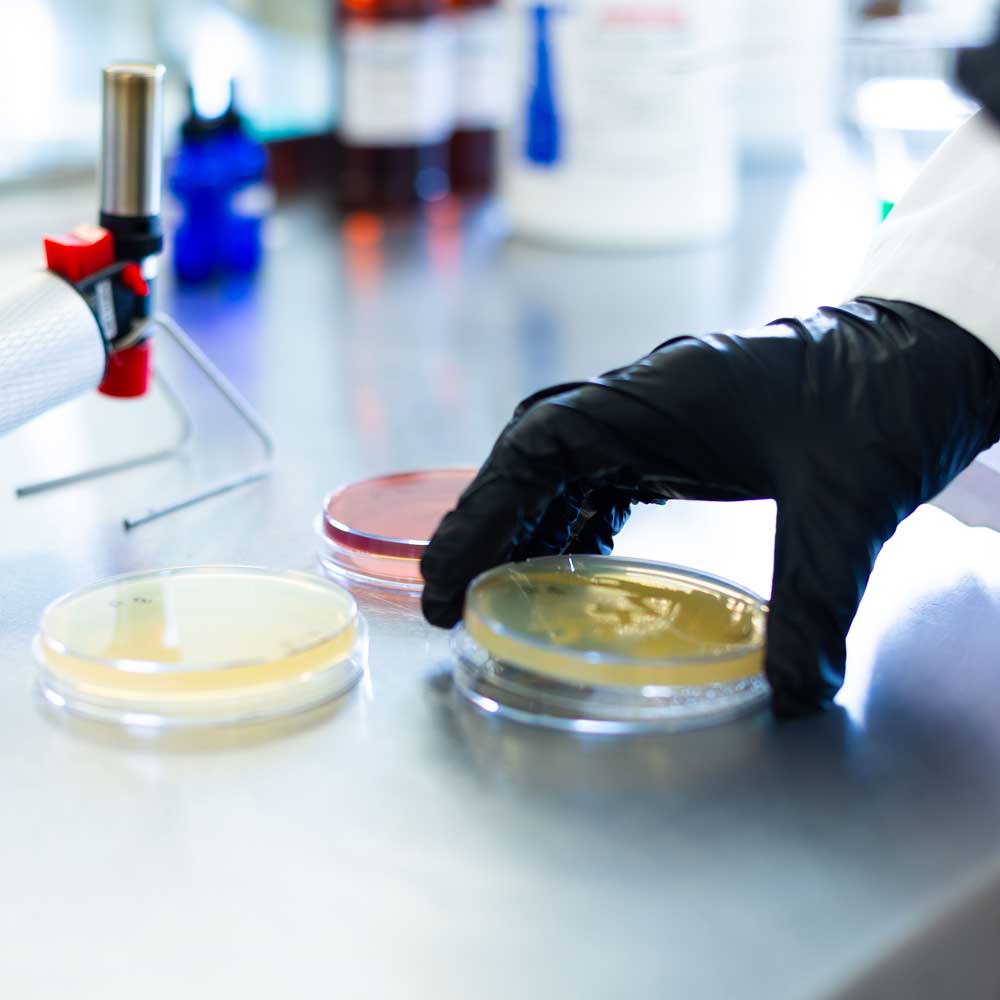
Petri dish Lab Testing

Maintaining a septic system is a critical responsibility for property owners, yet the internal workings of these systems are often misunderstood. When a septic system fails, the consequences are both messy and expensive. Replacing a leach field can cost tens of thousands of dollars and disrupt the use of a property for weeks. Many of these failures are driven by the accumulation of fats, oils, grease, and other organic solids that the system cannot process on its own. While the tank is the most visible part of the system, the health of the entire wastewater process depends on the invisible work of bacteria. Douglas ProTech provides BioStim microbial solutions as a science-backed method to manage these organic loads. This preventative care is essential for extending the lifespan of the system and protecting the environment.
How Septic Systems Fail
To understand failure, one must understand that a septic system consists of two primary parts: the tank and the leach field. The tank acts as a settling basin where solids sink to the bottom and grease floats to the top. The liquid in the middle, known as effluent, flows out to the leach field. The leach field is a network of perforated pipes buried in gravel-filled trenches. This is where the second and equally important step of wastewater processing occurs. The soil in the leach field acts as a natural filter, allowing bacteria in the ground to finalize the breakdown of waste.
Failure often occurs when the tank becomes overloaded with fats, oils, and grease (FOG). If these substances are not broken down within the tank, they escape into the leach field. Once in the soil, FOG creates a waterproof barrier called a biomat. This layer prevents water from filtering into the ground, causing the field to become saturated. Symptoms of a failing leach field include slow-running drains, foul odors around the property, and patches of unusually lush or soggy grass over the absorption area. Excessive pumping of the tank is often a sign that the leach field is no longer absorbing liquid properly.
The Importance of Leach Field Soil Health
Most maintenance efforts focus exclusively on the septic tank, but the health of the soil in the leach field is just as important. For a system to function, the soil must remain porous and biologically active. If the soil becomes compacted or contaminated by harsh chemicals, its ability to process effluent vanishes. Maintaining healthy soil involves more than just adding bacteria; it requires keeping heavy machinery off the field to prevent compaction and ensuring that only biodegradable materials enter the system. When both the tank and the field are maintained, major system failures are much less likely to occur. A healthy leach field is the final line of defense for your property’s wastewater management.

The Science Behind BioStim
BioStim is not a traditional chemical cleaner or a simple enzyme. It is a multi-strain, non-GMO microbial treatment containing naturally occurring bacteria specifically selected for their ability to digest complex organic matter. While enzymes only break large molecules into smaller ones, they do not actually remove the waste. In contrast, the bacteria in BioStim perform bioremediation. This is a biological process where the microbes consume fats, oils, grease, and proteins, converting them into harmless carbon dioxide and water.
Many homeowners turn to chemical or enzyme treatments when they notice a slow drain, but these can often make the problem worse. Harsh chemicals can kill the beneficial bacteria already living in the tank, while enzymes may simply liquefy grease and push it further into the leach field where it can reform and cause deeper blockages. BioStim formulations work with the natural biology of the system to provide a permanent reduction in organic solids. This scientific approach ensures that the waste is actually eliminated rather than just moved to another part of the system. It provides a sustainable environment for long-term septic health.
Application and Maintenance
Commercial and Residential Needs
In residential settings, the organic load is usually consistent, but commercial environments face much higher pressures. Apartments, resorts, and office buildings on septic systems often deal with high volumes of laundry waste, food scraps, and cleaning chemicals. These systems are significantly more prone to failure because the natural bacterial colonies cannot keep up with the influx of waste. For these commercial properties, a consistent microbial dosing schedule is the most effective way to prevent a catastrophic backup.
Dosage and Frequency
BioStim Septic Saver is sold as a concentrated powder that is easy to apply. For most systems, the powder is flushed down a toilet or added directly to the tank. Preventative dosing is much more effective than trying to use the product as an emergency fix for a total backup. Regular applications ensure that a high population of active bacteria is always present to handle new waste. We recommend following the specific dosage charts found in our BioStim Application Guidelines PDF. Consistency is the key to preventing the buildup of the restrictive biomat in the leach field.
Results and Benefits
The most immediate benefit of using BioStim is a reduced need for frequent tank pumping. By breaking down the solids and grease more efficiently, the volume of sludge in the tank grows much more slowly. This translates to direct cost savings over the life of the system. Additionally, properties using microbial treatments experience fewer odors and a lower risk of sewage backups into the building. Because the product is non-toxic and biodegradable, it is much safer for household plumbing and the surrounding groundwater than caustic chemical cleaners.
For property managers and homeowners, the greatest benefit is peace of mind. Knowing that the leach field is protected from FOG blockages means avoiding the stress of a failed inspection during a property sale or the sudden expense of a field replacement. BioStim is a cost-effective insurance policy against the most common causes of septic failure. It supports the natural water cycle by ensuring that treated water returns to the earth.
Why Choose BioStim and Douglas ProTech
Douglas ProTech takes a rigorous, lab-developed approach to wastewater management. Our BioStim products are managed by an on-staff microbiologist to ensure that the bacterial strains are potent and effective in real-world conditions. These formulas are field-proven in both small residential tanks and large-scale commercial processors. While we offer various microbial solutions in liquid or pill form for different industries, our Septic Saver is provided as a high-potency powder specifically for the needs of septic owners.
Protect your property’s wastewater infrastructure today. You can buy BioStim Septic Saver directly from us, download our application guide for detailed instructions, or contact us for a consultation regarding your commercial facility’s needs.
FAQ
Q: Is BioStim safe for all types of pipes? A: Yes. Because it uses natural bacteria rather than corrosive chemicals, it will not damage PVC, copper, or cast iron plumbing.
Q: How is this different from an enzyme treatment? A: Enzymes are biological catalysts that speed up reactions but are not alive. They break waste down but don’t “eat” it. BioStim contains live bacteria that consume the waste, removing it from the system entirely.
Q: How often should I use Septic Saver? A: For residential systems, a quarterly dose is typically sufficient. Commercial systems with higher grease loads may require more frequent applications to maintain healthy bacterial colonies.
Q: Can BioStim fix a leach field that is already completely clogged? A: While BioStim can help improve drainage in many cases, a field that has reached total failure may require physical intervention. It is best used as a preventative tool to keep the soil porous before a total blockage occurs.

